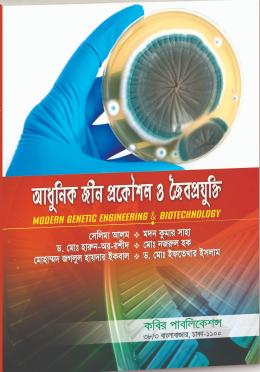

আধুনিক জীন প্রকৌশল ও জৈবপ্রযুক্তি (অনার্স ৪র্থ বর্ষ পাঠ্যবই)
(0 reviews)
Price:
৳355
/Pc
Share:
Top Selling Products
বইয়ের বিবরণী
বইয়ের নাম: আধুনিক জীন প্রকৌশল ও জৈবপ্রযুক্তি (অনার্স ৪র্থ বর্ষ পাঠ্যবই)
লেখক: সেলিম আলম, মদন কুমার সাহা, ডা: মো: হারুন অর রশিদ
বিভাগ/ শ্রেণী: অনার্স
There have been no reviews for this product yet.






















